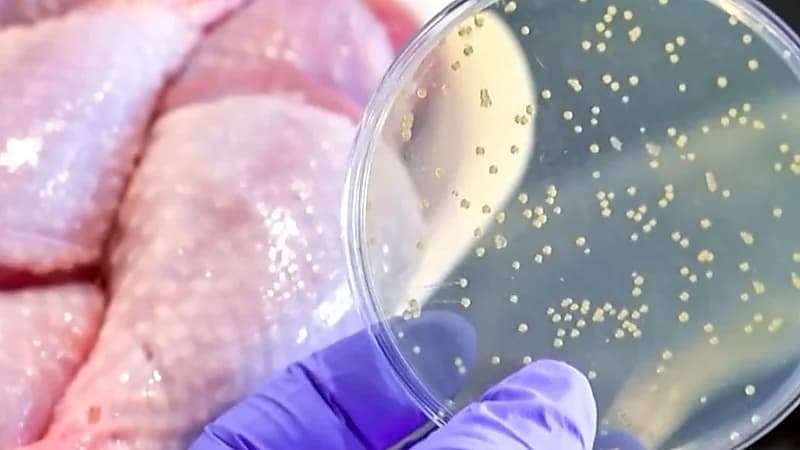
هل البكتيريا التي أصابت العشرات في الرياض تسبب الشلل ؟ استشاري يجيب .. فيديو

هل البكتيريا التي أصابت العشرات في الرياض تسبب الشلل ؟ استشاري يجيب .. فيديو
منذ 2 سنة04252
الرياض
أوضح استشاري أمراض معدية الدكتور أشرف دادا ، ما إذا كان التسمم النادر الذي أصاب حالات مطعم الرياض يسبب الشلل .
وقال أشرف خلال مداخلته مع قناة «العربية» : " السم الذي تفرزه البكتيريا سام جداً ويتفاعل مع إنزيم في الجسم وهو الذي يعطي الأعصاب القوة التي تتفاعل مع العضلات ثم تتحرك العضلات وعندما تشل هذه العلاقة بين العصب والعضل يؤدي إلى ضعف وربما شلل في هذه العضلات " .
وأضاف : " أكثر العضلات تأثراً بهذا السم هي عضلات الوجه والعين والفم وفي حالات نادرة جداً تسيب عضلات التنفس وهذه تعتبر حالة خطيرة " .
https://twitter.com/i/status/1784945824104886328






